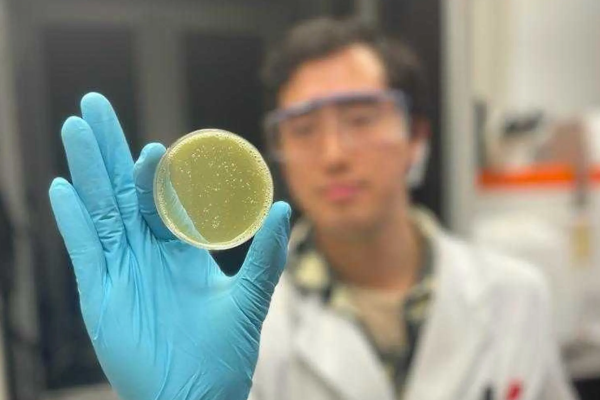

Dikişler ve zımbalar çoğu yarayı kapatmak için yeterli olsa da, hassas dokuya zarar verebilir ve iç organlara uygulandığında sıvıların dışarı sızmasına neden olabilir.
Bilim insanları bu nedenle doku lehimleme olarak bilinen alternatif bir yara kapatma yöntemini geliştirmeye başladılar.
Nanothermometry-Enabled Intelligent Laser Tissue Soldering
Doku lehimleme, jelatinimsi bir macunun yaranın sıkıştırılmış kenarlarına uygulandığı ve ardından lazerle ısıtıldığı deneysel bir tekniktir.
Isı, macunun polimerleşmesine ve alttaki dokudaki kollajene bağlanmasına neden olur ve yarayı iyileşene kadar kapalı tutan esnek, su geçirmez bir conta oluşturur. İşlem genellikle dikiş veya zımba uygulamaktan daha hızlı ve daha nazik olmakla kalmaz, aynı zamanda daha az iltihaplanma, daha az yara izi oluşmasına neden olur ve enfeksiyonlara karşı daha iyi koruma sağlar.
Bununla birlikte, macun doğru sıcaklığa ısıtılmazsa komplikasyonlar ortaya çıkabilir. Çok soğuksa dokuya tam olarak bağlanamaz, çok sıcaksa dokuyu yakar.

Bu sorunu çözmek amacıyla İsviçre’nin Empa ve ETH Zürih araştırma enstitülerinden bilim adamları, iSolder (akıllı lehim) adı verilen albümin bazlı bir macun geliştirdiler. Titanyum nitrür ve bizmut vanadat nanopartikülleri içerir; birincisi lazer ışığını ısıya dönüştürür, ikincisi ise belirli bir sıcaklığa ısıtıldığında floresans verir.
Bu nedenle, iSolder’ın jelatinimsi bir tabakası bir yaraya uygulandığında ve ardından lazer ışığına maruz bırakıldığında, alttaki dokuya bağlandığı doğru sıcaklığa ulaştığında gözle görülür şekilde parlayacaktır. Bu, doku kaynağında tahmine dayalı çalışmayı ortadan kaldırır; cerrahlar, macun parlayana kadar lazer ışığını uygulamaya devam eder, parlaklaştığında ise durur.
Zürih Üniversite Hastanesi, Cleveland Kliniği (ABD) ve Charles Üniversitesi’nden (Çek Cumhuriyeti) meslektaşlarıyla birlikte çalışan bilim insanları, bu teknolojiyi domuz yavrularının ince bağırsak, üretra, fallop tüpü ve böbrek damarındaki yaraları kapatmak için başarıyla kullandı. Ek bir avantaj olarak, kızılötesi ışığın potansiyel olarak zararlı lazer ışınlarına daha güvenli bir alternatif olarak kullanılabileceği keşfedildi.